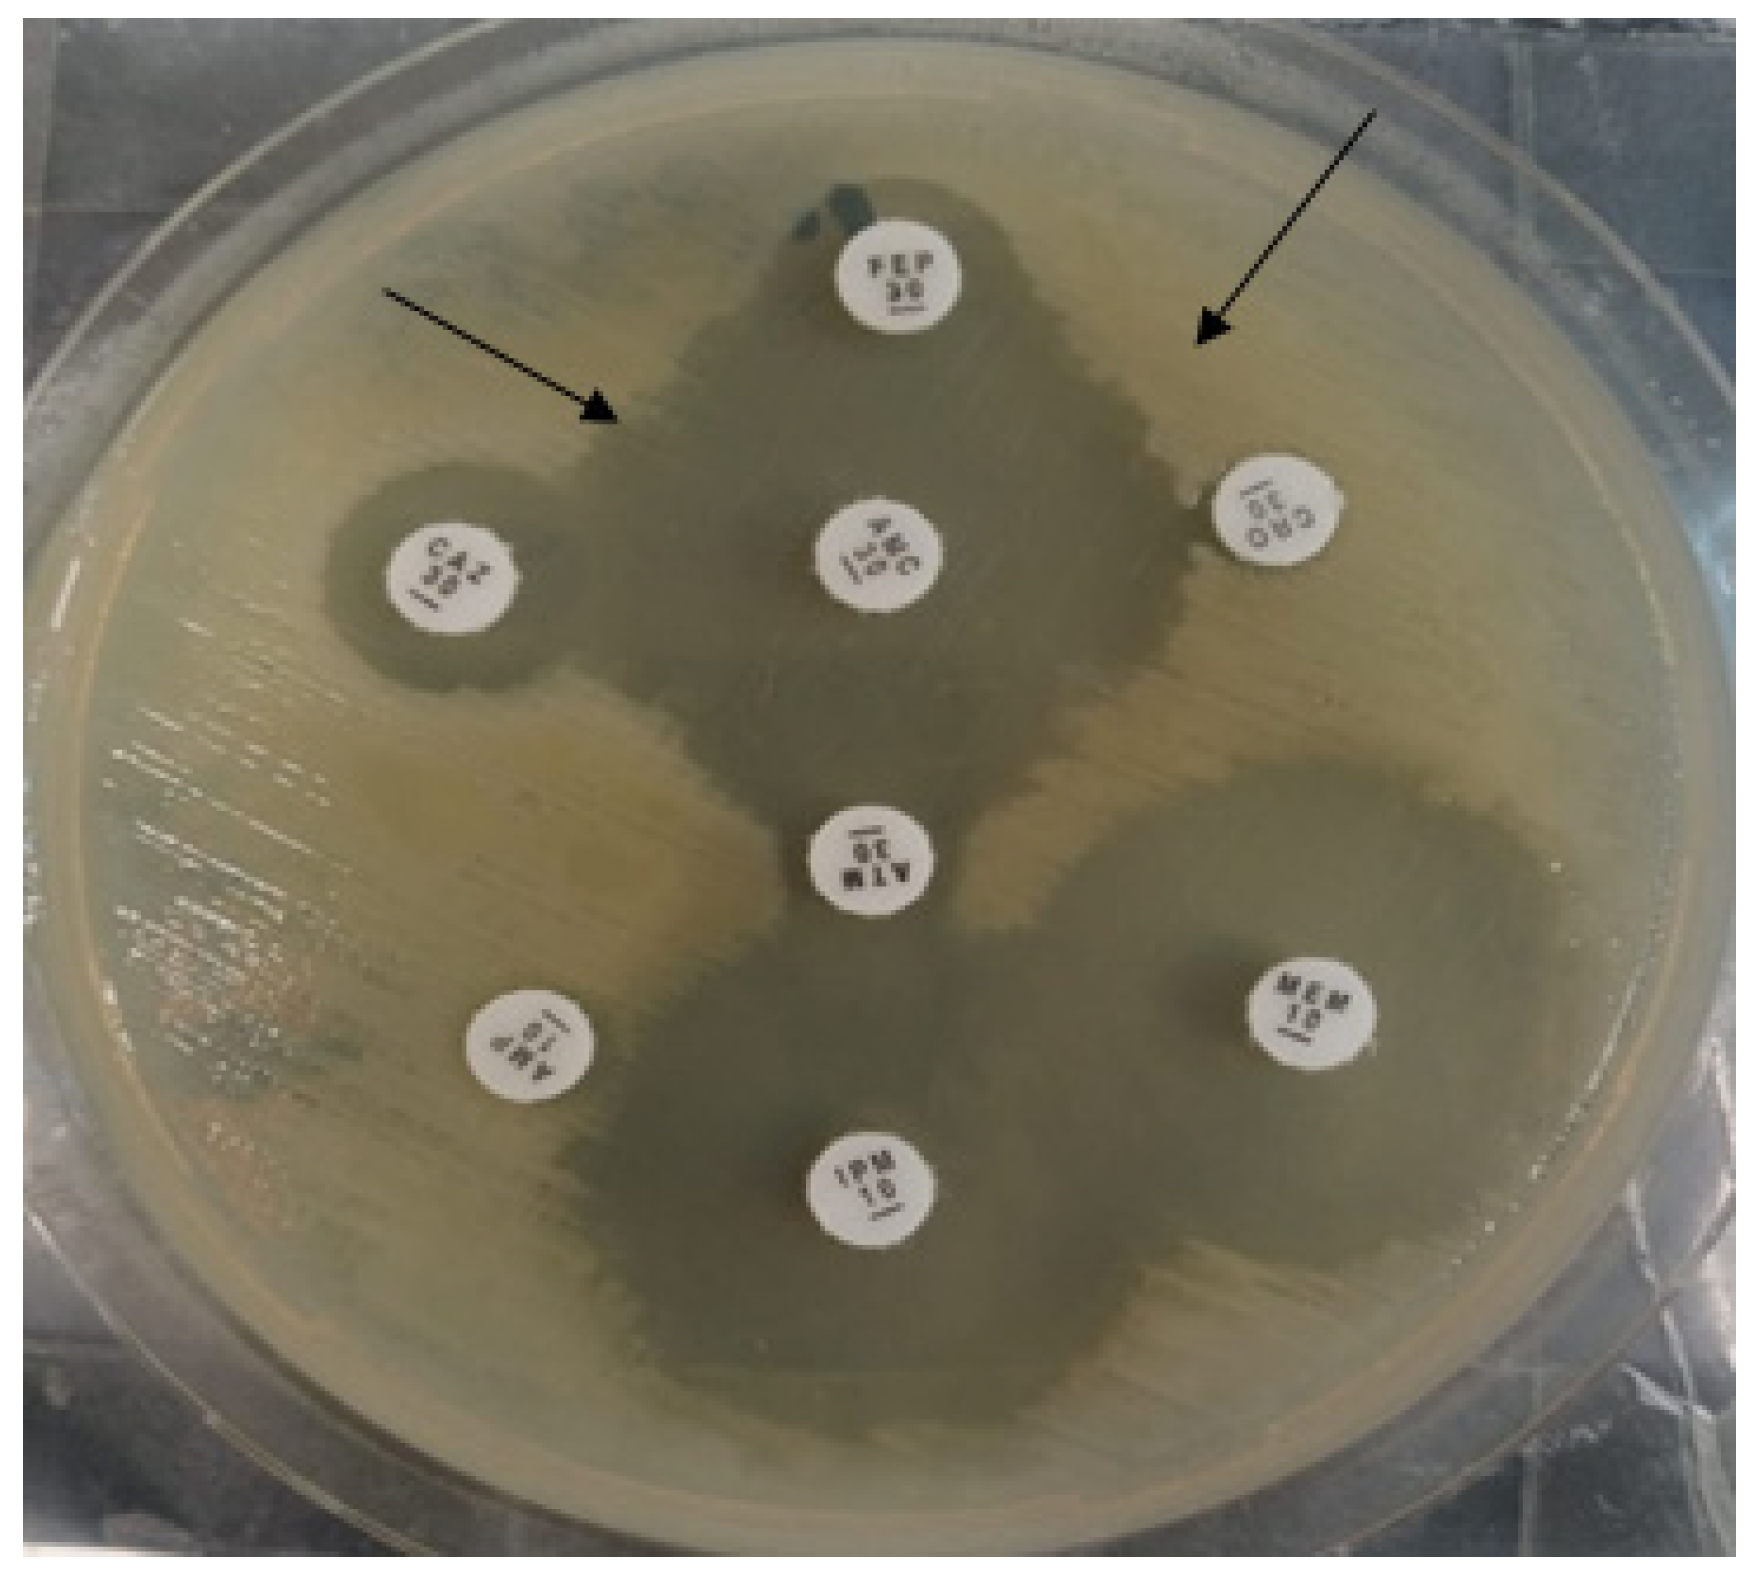

Antibacterial Efficacy of N-(4-methylpyridin-2-yl) Thiophene-2-Carboxamide Analogues against Extended-Spectrum-β-Lactamase Producing Clinical Strain of Escherichia coli ST 131
Abstract
1. Introduction
2. Results and Discussion
2.1. Chemistry
2.2. Confirmation of the Bacterial Isolate
2.3. Antibacterial Activity
2.4. Molecular Docking Studies
2.5. Molecular Dynamic (MD) Simulations of Highly Active Compounds
3. Materials and Methods
3.1. Antibacterial Activity
3.1.1. Identification of the Bacterial Strains
3.1.2. Antibiogram of the Isolates
3.1.3. Phenotypic Detection ESBL Enzyme
3.1.4. MLST of E. coli Strain
3.1.5. Molecular Detection of blaCTX-M Gene
3.1.6. Agar Well Diffusion Method of Compounds (4a–h) against ESBL-Producing E. coli
3.1.7. Minimum Inhibitory Concertation of Compounds (4a–h) against ESBL-Producing E. coli
3.1.8. Minimum Bactericidal Concentration of Compounds (4a–h) against ESBL-Producing E. coli
3.2. Molecular Docking
3.3. Molecular Dynamic (MD) Simulations
4. Conclusions
Supplementary Materials
Author Contributions
Funding
Institutional Review Board Statement
Informed Consent Statement
Data Availability Statement
Acknowledgments
Conflicts of Interest
References
- Usman Qamar, M.; S Lopes, B.; Hassan, B.; Khurshid, M.; Shafique, M.; Atif Nisar, M.; Mohsin, M.; Nawaz, Z.; Muzammil, S.; Aslam, B. The present danger of New Delhi metallo-β-lactamase: A threat to public health. Future Microbiol. 2020, 15, 1759–1778. [Google Scholar] [CrossRef] [PubMed]
- Thompson, T. The staggering death toll of drug-resistant bacteria. Nature 2022. [Google Scholar] [CrossRef] [PubMed]
- Miethke, M.; Pieroni, M.; Weber, T.; Brönstrup, M.; Hammann, P.; Halby, L.; Arimondo, P.B.; Glaser, P.; Aigle, B.; Bode, H.B. Towards the sustainable discovery and development of new antibiotics. Nat. Rev. Chem. 2021, 5, 726–749. [Google Scholar] [CrossRef] [PubMed]
- Asokan, G.V.; Ramadhan, T.; Ahmed, E.; Sanad, H. WHO global priority pathogens list: A bibliometric analysis of Medline-PubMed for knowledge mobilization to infection prevention and control practices in Bahrain. Oman Med. J. 2019, 34, 184. [Google Scholar] [CrossRef]
- Arshad, M.; Rasool, N.; Qamar, M.U.; Shah, S.A.A.; Zakaria, Z.A. Facile Synthesis of Functionalized Phenoxy Quinolines: Antibacterial Activities against ESBL Producing Escherichia coli and MRSA, Docking Studies, and Structural Features Determination through Computational Approach. Molecules 2022, 27, 3732. [Google Scholar] [CrossRef]
- Seyedjavadi, S.S.; Goudarzi, M.; Sabzehali, F. Relation between blaTEM, blaSHV and blaCTX-M genes and acute urinary tract infections. J. Acute Dis. 2016, 5, 71–76. [Google Scholar]
- Nicolas-Chanoine, M.-H.; Bertrand, X.; Madec, J.-Y. Escherichia coli ST131, an intriguing clonal group. Clin. Microbiol. Rev. 2014, 27, 543–574. [Google Scholar] [CrossRef]
- Rogers, B.A.; Sidjabat, H.E.; Paterson, D.L. Escherichia coli O25b-ST131: A pandemic, multiresistant, community-associated strain. J. Antimicrob. Chemother. 2011, 66, 1–14. [Google Scholar] [CrossRef]
- Pitout, J.D.; Peirano, G.; Chen, L.; DeVinney, R.; Matsumura, Y. Escherichia coli ST1193: Following in the Footsteps of E. coli ST131. Antimicrob. Agents Chemother. 2022, 66, e00511–e00522. [Google Scholar] [CrossRef]
- Clermont, O.; Lavollay, M.; Vimont, S.; Deschamps, C.; Forestier, C.; Branger, C.; Denamur, E.; Arlet, G. The CTX-M-15-producing Escherichia coli diffusing clone belongs to a highly virulent B2 phylogenetic subgroup. J. Antimicrob. Chemother. 2008, 61, 1024–1028. [Google Scholar] [CrossRef]
- Coque, T.M.; Novais, Â.; Carattoli, A.; Poirel, L.; Pitout, J.; Peixe, L.; Baquero, F.; Cantón, R.; Nordmann, P. Dissemination of clonally related Escherichia coli strains expressing extended-spectrum β-lactamase CTX-M-15. Emerg. Infect. Dis. 2008, 14, 195. [Google Scholar] [CrossRef]
- Colpan, A.; Johnston, B.; Porter, S.; Clabots, C.; Anway, R.; Thao, L.; Kuskowski, M.A.; Tchesnokova, V.; Sokurenko, E.V.; Johnson, J.R. Escherichia coli sequence type 131 (ST131) subclone H 30 as an emergent multidrug-resistant pathogen among US veterans. Clin. Infect. Dis. 2013, 57, 1256–1265. [Google Scholar] [CrossRef] [PubMed]
- Siddiqui, N.; Ahsan, W.; Alam, M.S.; Ali, R.; Srivastava, K. Design, Synthesis and Evaluation of Anticonvulsant Activity of Pyridinyl-Pyrrolidones: A Pharmacophore Hybrid Approach. Arch. Pharm. 2012, 345, 185–194. [Google Scholar] [CrossRef] [PubMed]
- Sarkar, K.; Khasimbi, S.; Mandal, S.; Dastidar, P. Rationally developed metallogelators derived from pyridyl derivatives of NSAIDs displaying anti-inflammatory and anticancer activities. ACS Appl. Mater. Interfaces. 2018, 10, 30649–30661. [Google Scholar] [CrossRef]
- Jo, J.-H.; Singh, N.; Kim, D.; Cho, S.M.; Mishra, A.; Kim, H.; Kang, S.C.; Chi, K.-W. Coordination-driven self-assembly using ditopic pyridyl–pyrazolyl donor and p-cymene Ru (II) Acceptors: [2]Catenane synthesis and anticancer activities. Inorg. Chem. 2017, 56, 8430–8438. [Google Scholar] [CrossRef] [PubMed]
- Peglow, T.J.; Schumacher, R.F.; Cargnelutti, R.; Reis, A.S.; Luchese, C.; Wilhelm, E.A.; Perin, G. Preparation of bis (2-pyridyl) diselenide derivatives: Synthesis of selenazolo [5, 4-b] pyridines and unsymmetrical diorganyl selenides, and evaluation of antioxidant and anticholinesterasic activities. Tetrahedron Lett. 2017, 58, 3734–3738. [Google Scholar] [CrossRef]
- Fu, C.; Pei, J.; Ning, Y.; Liu, M.; Shan, P.; Liu, J.; Li, Y.; Hu, F.; Zhu, Y.; Yang, H. Synthesis and insecticidal activities of novel pyrazole oxime ether derivatives with different substituted pyridyl rings. Pest Manag. Sci. 2014, 70, 1207–1214. [Google Scholar] [CrossRef] [PubMed]
- Muluk, M.B.; Phatak, P.S.; Pawar, S.B.; Dhumal, S.T.; Rehman, N.N.; Dixit, P.P.; Choudhari, P.B.; Haval, K.P. Synthesis, antimicrobial, and antioxidant activities of new pyridyl-and thiazolyl-bearing carbohydrazides. J. Chin. Chem. Soc. 2019, 66, 1507–1517. [Google Scholar] [CrossRef]
- Ondrejcak, T.; Wang, Q.; Kew, J.N.; Virley, D.J.; Upton, N.; Anwyl, R.; Rowan, M.J. Activation of α7 nicotinic acetylcholine receptors persistently enhances hippocampal synaptic transmission and prevents Aß-mediated inhibition of LTP in the rat hippocampus. Eur. J. Pharmacol. 2012, 677, 63–70. [Google Scholar] [CrossRef]
- Pollak, N.; Dölle, C.; Ziegler, M. The power to reduce: Pyridine nucleotides–small molecules with a multitude of functions. Biochem. J. 2007, 402, 205–218. [Google Scholar] [CrossRef]
- Iriepa, I.; Madrid, A.; Gálvez, E.; Bellanato, J. Synthesis, structural and conformational study of some amides derived from N-methylpiperazine. J. Mol. Struct. 2006, 787, 8–13. [Google Scholar] [CrossRef]
- Ouyang, X.; Armstrong, R.W.; Murphy, M.M. A novel cleavage technique to generate small molecule compounds and libraries via a two-resin system. J. Org. Chem. 1998, 63, 1027–1032. [Google Scholar] [CrossRef]
- Gudasi, K.B.; Vadavi, R.S.; Shenoy, R.V.; Patil, M.S.; Patil, S.A. Ambidentate behavior of pentadentate N, N′-bis (2-hydroxyphenyl)-pyridine-2, 6-dicarboxamide towards transition metal (II) salts. Transit. Met. Chem. 2005, 30, 569–574. [Google Scholar] [CrossRef]
- Auzeil, N.; Largeron, M.; Fleury, M.-B. Acid-catalysed N–alkyl heterolysis of tertiary pyridinecarboxamides and benzamides under mild conditions. J. Chem. Soc. Perkin Trans. 1999, 2, 1703–1710. [Google Scholar] [CrossRef]
- Bradford, P.A. Extended-spectrum β-lactamases in the 21st century: Characterization, epidemiology, and detection of this important resistance threat. Clin. Microbiol. Rev. 2001, 14, 933–951. [Google Scholar] [CrossRef] [PubMed]
- Mujahid, A.; Rasool, N.; Qamar, M.U.; Zubair, M.; Ahmad, F.; Altaf, A.A.; Akhtar, A.; Shah, S.A.A.; Alqahtani, F.; Alsanea, S. Arylation of halogenated thiophene carboxylate via Suzuki–Miyaura reaction: Anti-bacterial study against clinically isolated extensively drug resistant Escherichia coli sequence type 405 and computational investigation. Arab. J. Chem. 2022, 15, 103662. [Google Scholar] [CrossRef]
- Ahmad, G.; Rasool, N.; Qamar, M.U.; Alam, M.M.; Kosar, N.; Mahmood, T.; Imran, M. Facile synthesis of 4-aryl-N-(5-methyl-1H-pyrazol-3-yl) benzamides via Suzuki Miyaura reaction: Antibacterial activity against clinically isolated NDM-1-positive bacteria and their Docking Studies. Arab. J. Chem. 2021, 14, 103270. [Google Scholar] [CrossRef]
- Siddiqa, A.; Zubair, M.; Bilal, M.; Rasool, N.; Qamar, M.U.; Khalid, A.; Ahmad, G.; Imran, M.; Mahmood, S.; Ashraf, G.A. Synthesis of Functionalized N-(4-Bromophenyl) furan-2-carboxamides via Suzuki-Miyaura Cross-Coupling: Anti-Bacterial Activities against Clinically Isolated Drug Resistant A. baumannii, K. pneumoniae, E. cloacae and MRSA and Its Validation via a Computational Approach. Pharmaceuticals 2022, 15, 841–854. [Google Scholar]
- Ahmad, G.; Rasool, N.; Rizwan, K.; Imran, I.; Zahoor, A.F.; Zubair, M.; Sadiq, A.; Rashid, U. Synthesis, in-vitro cholinesterase inhibition, in-vivo anticonvulsant activity and in-silico exploration of N-(4-methylpyridin-2-yl) thiophene-2-carboxamide analogs. Bioorg. Chem. 2019, 92, 103216. [Google Scholar] [CrossRef]
- Batool, A.; Baig, H.; Qamar, M.U. Extended spectrum-β-lactamase producing Escherichia coli and Klebsiella pneumoniae causing urinary tract infection. Afr. J. Microbiol. Res. 2016, 10, 1775–1778. [Google Scholar]
- Ilyas, S.; Rasool, M.H.; Arshed, M.J.; Qamar, M.U.; Aslam, B.; Almatroudi, A.; Khurshid, M. The Escherichia coli sequence type 131 harboring extended-spectrum beta-lactamases and carbapenemases genes from poultry birds. Infect. Drug Resist. 2021, 14, 805. [Google Scholar] [CrossRef]
- Bajaj, P.; Singh, N.S.; Virdi, J.S. Escherichia coli β-lactamases: What really matters. Front. Microbiol. 2016, 7, 417. [Google Scholar] [CrossRef] [PubMed]
- Maryam, L.; Khan, A.U. A mechanism of synergistic effect of streptomycin and cefotaxime on CTX-M-15 type β-lactamase producing strain of E. cloacae: A first report. Front. Microbiol. 2016, 7, 2007. [Google Scholar] [CrossRef] [PubMed]
- Maryam, L.; Khan, A.U. Combination of aztreonam and cefotaxime against CTX-M-15 type β-lactamases: A mechanism based effective therapeutic approach. Int. J. Biol. Macromol. 2018, 116, 1186–1195. [Google Scholar] [CrossRef]
- Hinchliffe, P.; Tooke, C.L.; Bethel, C.R.; Wang, B.; Arthur, C.; Heesom, K.J.; Shapiro, S.; Schlatzer, D.M.; Papp-Wallace, K.M.; Bonomo, R.A. Penicillanic Acid Sulfones Inactivate the Extended-Spectrum b-Lactamase CTX-M-15 through Formation of a Serine-Lysine Cross-Link: An Alternative Mechanism of b-Lactamase Inhibition. Mbio 2022, 13, e01793-21. [Google Scholar] [CrossRef] [PubMed]
- Madej, T.; Lanczycki, C.J.; Zhang, D.; Thiessen, P.A.; Geer, R.C.; Marchler-Bauer, A.; Bryant, S.H. MMDB and VAST+: Tracking structural similarities between macromolecular complexes. Nucleic Acids Res. 2014, 42, D297–D303. [Google Scholar] [CrossRef] [PubMed]
- CcG, C. Molecular Operating Environment (MOE); Chem Comput Gr Inc.: Montreal, QC, Canada, 2016. [Google Scholar]
- Kelly, K. 3D Bioinformatics and Comparative Protein Modeling in MOE; Chem Comput Group: Montreal, QC, Canada, 2013; pp. 1–10. [Google Scholar]
- Molecular Operating Environment (MOE). Chemical Computing Group ULC, 1010 Sherbooke St. West, Suite# 910; MOE: Montreal, QC, Canada, 2019. [Google Scholar]
- Cuzzolin, A.; Sturlese, M.; Malvacio, I.; Ciancetta, A.; Moro, S.; Ragno, R. DockBench: An integrated informatic platform bridging the gap between the robust validation of docking protocols and virtual screening simulations. Molecules 2015, 20, 9977–9993. [Google Scholar] [CrossRef] [PubMed]
- Attique, S.A.; Hassan, M.; Usman, M.; Atif, R.M.; Mahboob, S.; Al-Ghanim, K.A.; Bilal, M.; Nawaz, M.Z. A molecular docking approach to evaluate the pharmacological properties of natural and synthetic treatment candidates for use against hypertension. Int. J. Environ. Res. Public Health 2019, 16, 923. [Google Scholar] [CrossRef]
- Biovia, D.S. Discovery Studio Modeling Environment. Release: 2017. Available online: https://www.3ds.com/ (accessed on 10 December 2022).
- Van Der Spoel, D.; Lindahl, E.; Hess, B.; Groenhof, G.; Mark, A.E.; Berendsen, H.J. GROMACS: Fast, flexible, and free. J. Comput. Chem. 2005, 26, 1701–1718. [Google Scholar] [CrossRef]
- Assadollahi, V.; Rashidieh, B.; Alasvand, M.; Abdolahi, A.; Lopez, J.A. Interaction and molecular dynamics simulation study of Osimertinib (AstraZeneca 9291) anticancer drug with the EGFR kinase domain in native protein and mutated L844V and C797S. J. Cell. Biochem. 2019, 120, 13046–13055. [Google Scholar] [CrossRef]

| Antibiotics | WHO Antibiotic Classification | Antibiotic Class | MIC Breakpoints (ug/mL) | E. coli |
|---|---|---|---|---|
| AMP | Access | Penicillins | ≤8–≥32 | ≥512 |
| PIP | Watch | Penicillins | ≤16–≥128 | ≥512 |
| CRO | Watch | Third-generation-cephalosporins | ≤1–≥4 | ≥256 |
| CAZ | Watch | Third-generation-cephalosporins | ≤4–≥16 | ≥256 |
| FEP | Watch | Fourth-generation-cephalosporins | ≤2–≥16 | ≥128 |
| CFT | Reserve | Fifth-generation-cephalosporins | ≤0.5–≥2 | ≥8 |
| ATM | Reserve | Monobactams | ≤4–≥16 | ≥64 |
| IMP | Watch | Carbapenem | ≤1–≥4 | 2 |
| MEM | Watch | Carbapenem | ≤1–≥4 | 2 |
| AK | Watch | Aminoglycosides | ≤16–≥64 | 32 |
| LEV | Watch | Fluoroquinolones | ≤0.5–≥2 | ≥16 |
| CIP | Watch | Fluoroquinolones | ≤0.25–≥1 | ≥8 |
| MNO | Watch | Fluoroquinolones | ≤4–≥16 | ≥64 |
| SXT | Access | Sulfonamide-trimethoprim-combinations | ≤2/38–≥4/76 | ≥4/152 |
| F | Access | Nitrofuran-derivatives | ≤32–≥128 | 16 |
| FOS | Reserve | Phosphonics | ≤64–≥156 | 32 |
| CS | Reserve | Polymyxins | ≥4 | 0.5 |
| Compound No. | Zone (mm) (50 mg/mL) | Zone (mm) (40 mg/mL) | Zone (mm) (30 mg/mL) | Zone (mm) (20 mg/mL) | Zone (mm) (10 mg/mL) | Zone (mm) DMSO |
|---|---|---|---|---|---|---|
| 4a | 13 ± 2 | 12 ± 2 | 10 ± 2 | 8 ± 2 | 6 ± 2 | 0 |
| 4b | 12 ± 2 | 9 ± 2 | 8 ± 2 | 7 ± 2 | 6 ± 2 | 0 |
| 4c | 15 ± 2 | 13 ± 2 | 10 ± 2 | 9 ± 2 | 7 ± 2 | 0 |
| 4d | 10 ± 2 | 9 ± 2 | 8 ± 2 | 7 ± 2 | 4 ± 2 | 0 |
| 4e | 12 ± 2 | 10 ± 2 | 8 ± 2 | 7 ± 2 | 5 ± 2 | 0 |
| 4f | 10 ± 2 | 8 ± 2 | 7 ± 2 | 6 ± 2 | 5 ± 2 | 0 |
| 4g | 12 ± 2 | 10 ± 2 | 9 ± 2 | 8 ± 2 | 7 ± 2 | 0 |
| 4h | 11 ± 2 | 10 ± 2 | 8 ± 2 | 6 ± 2 | 4 ± 2 | 0 |
| Compound No. | MIC (mg/mL) | MBC (mg/mL) |
|---|---|---|
| 4a | 3.125 | 6.25 |
| 4b | 12.5 | 25 |
| 4c | 3.125 | 6.25 |
| 4d | 6.25 | 12.5 |
| 4e | 25 | 50 |
| 4f | 6.25 | 12.5 |
| 4g | 6.25 | 12.5 |
| 4h | 25 | 50 |
Disclaimer/Publisher’s Note: The statements, opinions and data contained in all publications are solely those of the individual author(s) and contributor(s) and not of MDPI and/or the editor(s). MDPI and/or the editor(s) disclaim responsibility for any injury to people or property resulting from any ideas, methods, instructions or products referred to in the content. |
© 2023 by the authors. Licensee MDPI, Basel, Switzerland. This article is an open access article distributed under the terms and conditions of the Creative Commons Attribution (CC BY) license (https://creativecommons.org/licenses/by/4.0/).
Share and Cite
Ahmad, G.; Khalid, A.; Qamar, M.U.; Rasool, N.; Saadullah, M.; Bilal, M.; Bajaber, M.A.; Obaidullah, A.J.; Alotaibi, H.F.; Alotaibi, J.M. Antibacterial Efficacy of N-(4-methylpyridin-2-yl) Thiophene-2-Carboxamide Analogues against Extended-Spectrum-β-Lactamase Producing Clinical Strain of Escherichia coli ST 131. Molecules 2023, 28, 3118. https://doi.org/10.3390/molecules28073118
Ahmad G, Khalid A, Qamar MU, Rasool N, Saadullah M, Bilal M, Bajaber MA, Obaidullah AJ, Alotaibi HF, Alotaibi JM. Antibacterial Efficacy of N-(4-methylpyridin-2-yl) Thiophene-2-Carboxamide Analogues against Extended-Spectrum-β-Lactamase Producing Clinical Strain of Escherichia coli ST 131. Molecules. 2023; 28(7):3118. https://doi.org/10.3390/molecules28073118
Chicago/Turabian StyleAhmad, Gulraiz, Aqsa Khalid, Muhammad Usman Qamar, Nasir Rasool, Malik Saadullah, Muhammad Bilal, Majed A. Bajaber, Ahmad J. Obaidullah, Hadil Faris Alotaibi, and Jawaher M. Alotaibi. 2023. "Antibacterial Efficacy of N-(4-methylpyridin-2-yl) Thiophene-2-Carboxamide Analogues against Extended-Spectrum-β-Lactamase Producing Clinical Strain of Escherichia coli ST 131" Molecules 28, no. 7: 3118. https://doi.org/10.3390/molecules28073118
APA StyleAhmad, G., Khalid, A., Qamar, M. U., Rasool, N., Saadullah, M., Bilal, M., Bajaber, M. A., Obaidullah, A. J., Alotaibi, H. F., & Alotaibi, J. M. (2023). Antibacterial Efficacy of N-(4-methylpyridin-2-yl) Thiophene-2-Carboxamide Analogues against Extended-Spectrum-β-Lactamase Producing Clinical Strain of Escherichia coli ST 131. Molecules, 28(7), 3118. https://doi.org/10.3390/molecules28073118

